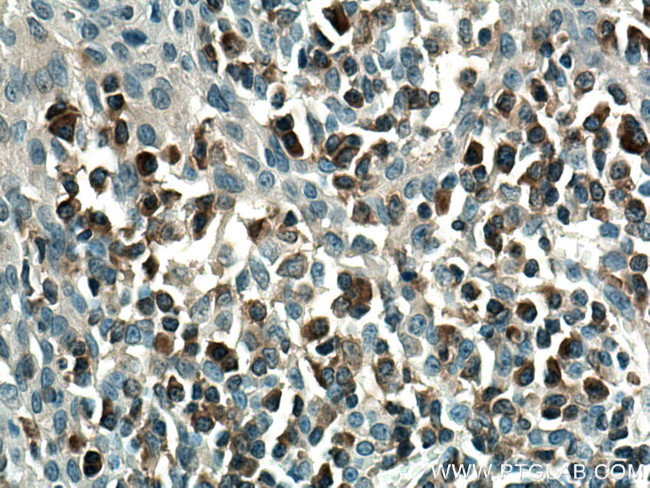
PLCG2 Antibody in Immunohistochemistry (Paraffin) (IHC (P))

Search
Proteintech
PLCG2 Monoclonal Antibody (2F8H5)
{{$productOrderCtrl.translations['antibody.pdp.commerceCard.promotion.promotions']}}
{{$productOrderCtrl.translations['antibody.pdp.commerceCard.promotion.viewpromo']}}
{{$productOrderCtrl.translations['antibody.pdp.commerceCard.promotion.promocode']}}: {{promo.promoCode}} {{promo.promoTitle}} {{promo.promoDescription}}. {{$productOrderCtrl.translations['antibody.pdp.commerceCard.promotion.learnmore']}}
产品信息
67011-1-IG
种属反应
宿主/亚型
分类
类型
克隆号
抗原
偶联物
形式
浓度
纯化类型
保存液
内含物
保存条件
运输条件
产品详细信息
Aliquoting is unnecessary for -20°C storage.
靶标信息
Phosphoinositide-specific phospholipase C (PLC) plays a crucial role in the initiation of receptor mediated signal transduction through the generation of the two second messengers, inositol 1,4,5-triphosphate and diacylglycerol from phosphatidylinositol 4,5-bisphosphate. There are many mammalian PLC isozymes, including PLC beta1, PLC beta2, PLC beta3, PLC beta4, PLC gamma1, PLC gamma2, PLC delta1, PLC delta2 and PLCe. PLC delta exists as four different isoforms. PLC delta1, a calcium signal amplifier, is activated by an atypical GTP-binding protein. In addition, PLC delta1 is an effector for GTP-binding protein transglutaminase II-mediated oxytocin receptor and alpha1B-adrenoreceptor signaling. Mouse PLC delta1 is highly expressed in brain, heart, lung and testis. PLC delta is abnormally accumulated in autopsied brains with Alzheimer's disease (AD), suggesting that it may play a role in the pathology of AD. PLC delta2 is markedly expressed in type II intestinal metaplasia and in the adenocarcinoma. When PLC delta2 is expressed in type I intestinal metaplasia, the metaplasia is generally considered benignant, yet evolves toward neoplastic transformation. Thus, PLC delta2 expression may be a possible marker of gastric malignant transformation.
仅用于科研。不用于诊断过程。未经明确授权不得转售。
篇参考文献 (0)
生物信息学
蛋白别名: 1-phosphatidylinositol 4,5-bisphosphate phosphodiesterase gamma-2; Phosphoinositide phospholipase C-gamma-2; phospholipase C, gamma 2 (phosphatidylinositol-specific); Phospholipase C-gamma-2; Phospholipase C-IV; PLC gamma 2; PLC gamma-2; PLC gamma2; PLC- gamma2; PLC-gamma; PLC-gamma-2; PLC-IV
基因别名: APLAID; FCAS3; PLC-gamma-2; PLC-IV; PLCG2
UniProt ID: (Human) P16885
Entrez Gene ID: (Human) 5336